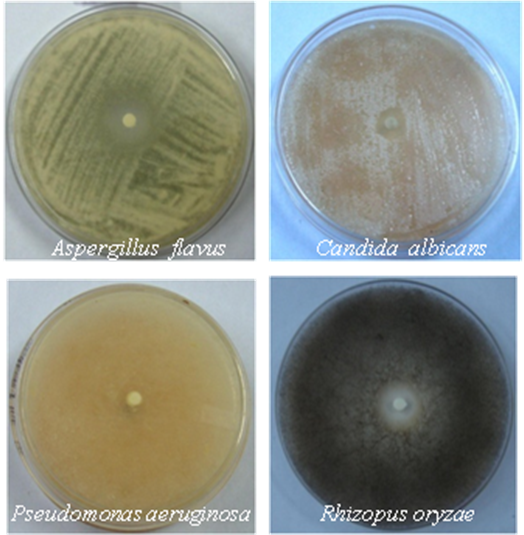

1Centre of Biotechnology, Siksha O Anusandhan University, Kalinga Nagar, Ghatikia, Bhubaneswar 751003, Odisha, India, 2P.G. Department of Botany Utkal University, Vanivihar, Bhubaneswar, Odisha, India.
Email: sujatamohantyils@gmail.com
Received: 10 May 2014 Revised and Accepted: 20 June 2014
ABSTRACT
Objective: GC and GC MS based analysis of the essential oil from leaf samples of Ocimum americanum were done. The essential oil composition, In vitro antioxidant and antimicrobial activity of the essential oil of O. americanum were evaluated in this research to explore its potential for future use.
Methods: The component identification was achieved by the GC–MS analysis. Radical-scavenging activities of the plant essential oil were determined by 2, 2-diphenyl-1-picrylhydrazyl (DPPH) activity. Antimicrobial activity of the essential oil was done using standard pathogenic strains in disc diffusion method.
Results: GC and GC/MS analysis of the plant essential oil resulted in the identification of 19 compounds representing 100% of the oil. Citral (47.18%) and β - citral (36.57%) were the two major constituents. The essential oil subjected to analysis of its antioxidant activity using 2, 2- diphenyl-1-1picrylhydrazyl (DPPH) showed higher activity as compared to the standard. The oil was also screened for its antimicrobial activity and the inhibition was recorded against pathogenic microorganisms.
Conclusion: Both the antimicrobial and anti oxidant activity of Ocimum americanum showed its potential for further use as natural antioxidant and preservative. Essential oil from the medicinal plants is one of the promising natural compounds for preparation of safer antimicrobial and antioxidant agent. Antioxidants conventionally used in food industries are obtained by chemical synthesis, but their use, reserved for certain categories of food is regulated by dose limits. Leaves of Ocimum americanum L. contain citral rich essential oil which is a potent source for natural antioxidants and biologically active compounds.
Keywords: Ocimum americanum, GC MS analysis, Antioxidant activity, Antimicrobial activity.
INTRODUCTION
Ocimum americanum L. (Lamiaceae) commonly known as lime basil is an annual plant native to Asia and Africa which grows under full sun to partly shady conditions in average soils. It is a wild herb with a distinct mint flavor, hairy leaves and scented flowers that have received considerable attention for their potential medicinal properties. The leaf juice has been used in traditional folk medicine for the treatment of diabetes, constipation, diarrhea, piles and dysentery. Besides, the leaves are also reported to have mosquito repellant, larvicidal activity and hepatoprotective activity [1, 2]. The leaf is rich in essential oils of therapeutic importance and mostly used as a condiment for the preparation of delicious local soup, salad and tea because of its aromatic properties [3].
The oil has antibacterial and antifungal activity against a great number of microorganisms including some human pathogens. Essential oil from medicinal plants is one of the promising natural compounds for preparation of safer antimicrobial and antioxidant agent. Antioxidants conventionally used in food industries are obtained by chemical synthesis, but their use, reserved for certain categories of food is regulated by dose limits. The trend led to the use of natural antioxidants belonging to various chemical families’ i.e. phenolic compounds, tocopherols and ascorbic acid. In recent years, increasing attention has been paid to the exploration of naturally-occurring antioxidants because of the growing consumer demand for food products free from synthetic chemical additives [4]. In recent years, the essential oils and herbal extracts have attracted a great deal of scientific interest due to their potential as a source of natural antioxidants and biologically active compounds [5]. The antimicrobial and antioxidant activities of essential oils have many applications, including fresh and processed food preservation, pharmaceuticals, alternative medicine and natural therapies [6, 7]. Though the antimicrobial activity of essential oil against microorganisms has been investigated by many researchers for medical purposes but no information is available regarding its potential as a natural antioxidant. Thus the present work of antioxidant and antimicrobial activity of O. americanum is of great importance.
MATERIALS AND METHODS
Collection of plant material
Ocimum americanum plants were collected from wild forest areas and were grown in Botanical garden of Utkal University, Bhubaneswar, Odisha, India. The fresh leaves were gathered from plants and were used for extraction of essential oil.
Extraction and GC–MS analysis of essential oil
Leaf oil of O. americanum plants was extracted by hydro-distillation in a Clevenger’s apparatus up to 3 hours following the method of [8]. The component identification was achieved by the GC–MS analysis using HP 6890 series GC (Hewlett-Packard, USA) coupled with a mass selective detector (MSD), HP 5973 series (Hewlett-Packard). Helium was used as a carrier gas and the sample was injected in split less mode in a column HP5 phenyl methyl siloxane [25 µm (film thickness) × 320 µm (internal diameter) × 30 m (length of column)]. Mass spectra were acquired over a 40–400 atomic mass unit range. Compounds after GC-MS analysis were identified by comparing the mass spectral data with those present in the NIST library provided with software and with commercially available data. Temperature programming was set as initial temperature at 60°C, ramping rate at 3°C, final temperature at 243°C and run time was for 61 min. For GC MS analysis 20 plants were selected randomly from the garden. Data were subjected to analysis of variance for a factorial experiment. Critical differences (CD) were calculated to determine the statistical significance of different means.
Collection of microbial strains
The tested microorganisms were obtained from the Microbial Type Culture Collection, Chandigarh, India. The organisms were Aspergillus flavus (MTCC 3783), Candida albicans (MTCC 854), Escherichia coli (MTCC 119), Fusarium oxysporum (MTCC 7229), Pseudomonas aeruginosa (MTCC 741), Rhizopus oryzae (MTCC 8784), Staphylococcus aureus (MTCC 9011) and Streptococcus mutans (MTCC 497). All these cultures were maintained on Muller Hinton Agar (MHA) and nutrient agar (NA) then incubated overnight at 37 ºC. Then these cultures were further used for antimicrobial studies.
Disc diffusion assay to determine zone of inhibition (ZOI)
The growth potential of microorganisms was determined using disc diffusion method as done earlier by [9]. For this freshly prepared microbial culture plates were used and tests were performed in triplicates. Inoculated plates containing microorganisms were taken and above it filter discs (6mm diameter) soaked in leaf essential oil (25 µl) was inserted. These were kept overnight for 24 hour incubation at 37 ºC. The zone of inhibition was measured in a zone measuring scale after one day incubation period.
DPPH radical scavenging assay
The 2, 2-diphenyl-1-picrylhydrazyl (DPPH) radical assays usually involve hydrogen atom transfer reactions but based on kinetic data an electron transfer mechanism has also been suggested [10]. Radical-scavenging activities of the plant essential oil were determined by following the protocol with minor modifications [11]. Dilutions were made to obtain concentrations ranging from 1 to 100 µg/ml. Diluted solutions of sample (1 ml each) were mixed with 1 ml of a freshly prepared DPPH radical methanol solution and allowed to stand for 30 min in the dark at room temperature for any reaction to take place. Absorbance values of these solutions were recorded on an ultraviolet and visible spectrometer at 517 nm using a blank without oil samples. Inhibitions of DPPH radical in percent (I %) was calculated as follow:
I %=Ablank _ Asample/Ablank × 100
Where Ablank is the absorbance value of the control reaction (containing all reagents except the test sample) and Asample is the absorbance values of the test sample. The sample concentration providing 50% inhibition (IC50) was calculated by plotting inhibition percentages against concentrations of the sample. All tests were carried out in triplicates and IC50 values were reported as means ± SD of triplicates.
Table 1: Chemical composition by GC-MS analysis of leaf oil in Ocimum americanum
| S. No. | Oil constituents | Molecular Formula | RI | Area % |
| 1 | Linalyl alcohol | C10H16 | 1102 | 2.03 |
| 2 | Vinylcyclooctane | C10H14 | 1470 | 0.85 |
| 3 | Vinylcyclohexane | C10H18O | 1490 | 1.41 |
| 4 | β-Citral | C10H16 | 1230 | 36.57 |
| 5 | Citral | C10H16 | 1260 | 47.18 |
| 6 | Nerol acetate | C10H16O | 1760 | 0.32 |
| 7 | Cyclopentane,methylene | C10H18O | 925 | 2.14 |
| 8 | Caryophyllene | C10H18O | 1430 | 1.05 |
| 9 | α-Bergamotene | C10H18O | 1421 | 0.94 |
| 10 | Humulene | C10H16 | 1441 | 0.51 |
| 11 | D-Germacrene | C15H24 | 1700 | 1.40 |
| 12 | α-Selinene | C15H24 | 1521 | 0.37 |
| 13 | Bicyclogermacrene | C15H24 | 1731 | 0.92 |
| 14 | β-Elemene | C15H24 | 1581 | 0.24 |
| 15 | α-Bulnesene | C15H24 | 1508 | 0.46 |
| 16 | Cis-α-Bisabolene | C15H24 | 1539 | 2.67 |
| 17 | (-)-Spathulenol | C15H24 | 1641 | 0.31 |
| 18 | β-Selinenol | C15H26O | 1646 | 0.19 |
RESULTS AND DISCUSSION
Extraction of essential oil and GC-MS analysis
The essential oil extracted by hydro distillation from the leaves of Ocimum americanum gave yellowish oil with lemon flavor with a yield of 0.2 % (w/v). Quantitative analysis of essential oil by GC and GC-MS analysis resulted in eighteen components amounting to 99.56% (Table 1).The oil was dominated by Citral (47.18 %) and β-citral (36.57 %) followed by others as minor constituents (Figure 1). There are reports on the chemical constituents of O. americanum from north western Himalayan region [12]. Depending upon the chemical constituents and cluster analysis six groups were reported with difference in their major compounds. In contrast to their report, in our plants the major constituent was citral. Variation in chemical constituents may be due to genetic, ecological or individual variability [5, 13, 14, 15]. To the best of our knowledge there are no other reports on the constituent analysis of O. americanum essential oil, though reports are available on its antimicrobial and hepatoprotective activity [2, 16].
Antioxidant activity
The antioxidant activity may be due to different mechanisms, such as prevention of chain initiation, decomposition of peroxides and prevention of continued hydrogen abstraction, free radical scavenging, reducing capacity, and binding of transition metal ion catalysts [17]. Thus the radical scavenging activity of DPPH radicals formation was determined by the decrease in its absorbance at 517 nm induced by antioxidants.

Fig. 1: GC-MS analysis of leaf essential oil in Ocimum americanum
DPPH is a stable free radical and accept an electron or hydrogen radical to become a stable diamagnetic molecule [18]. The free radical scavenging activity of essential oil was evaluated as described by [19]. The scavenging ability of cell sample showed a concentration dependent activity profile (Figure 2).

Fig. 2: DPPH radical scavenging activity of leaf essential oil in O. americanum
The oil showed very good activity in comparison to the standard taken that is ascorbic acid. As per the available literature antioxidant activity of O. americanum essential oil has not previously been reported but antioxidant activity of essential oil and extracts has been reported in other Ocimum species [20, 21, 22]. Hence the present report could be assumed as the first report on antioxidant activity of O. americanum essential oil.
Antimicrobial activity
In our study, the essential oil of O. americanum tested against all microorganisms showed a zone of inhibition ranging from 2-18 mm (Figure 3). The maximum zone formation was 18 mm seen in Rhizopus oryzae followed by Aspergillus flavus, Candida albicans and Pseudomonas aeruginosa (Table 2). The first report on antimicrobial activity of essential oil of O. americanum was done against oral microorganisms [23]. In their study only three microorganisms were tested as S. mutans, L. casei and C. albicans which revealed that by using this essential oil in oral health products the pathogen attack in oral cavity can be reduced which would be beneficial. Antimicrobial activity in other Ocimum species was reported by many workers [5, 14, 24]. It was observed that essential oil from O. americanum posses both antioxidant activity and antimicrobial activity against pathogenic microbes. To the best of our knowledge, this is the first report on antioxidant activity of O. americanum essential oil. The production of essential oils and their utilization as potential natural food preservative could be of economical value. However further studies are needed to comment more in this aspect. However O. americanum essential oil could be of immense potential to be used in food, medicinal and cosmetics purposes.
Table 2: Antimicrobial activity of the leaf essential oil of O. americanum against microorganisms
| S. No. | Microorganisms | Zone of inhibition (mm) in essential oil (Mean ± SD) |
| 1 | Aspergillus flavus | 16 ± 0.08 |
| 2 | Candida albicans | 11 ± 0.12 |
| 3 | Escherichia coli | 2 ± 0.15 |
| 4 | Fusarium oxysporum | 4 ± 0.07 |
| 5 | Pseudomonas aeruginosa | 10 ± 0.21 |
| 6 | Rhizopus oryzae | 18 ± 0.16 |
| 7 | Staphylococcus aureus | 2 ± 0.08 |
| 8 | Streptococcus mutans | 3 ± 0.07 |
Fig. 3: Antimicrobial activity of citral rich leaf essential oil of O. americanum
ACKNOWLEDGEMENTS
The authors are grateful to Dr. Manoj Ranjan Nayak, President, Center of Biotechnology, Siksha O Anusandhan University, for providing all the facilities.
NO DECLARATIONS OF INTEREST
CONFLICT OF INTERESTS
Declared None
REFERENCES